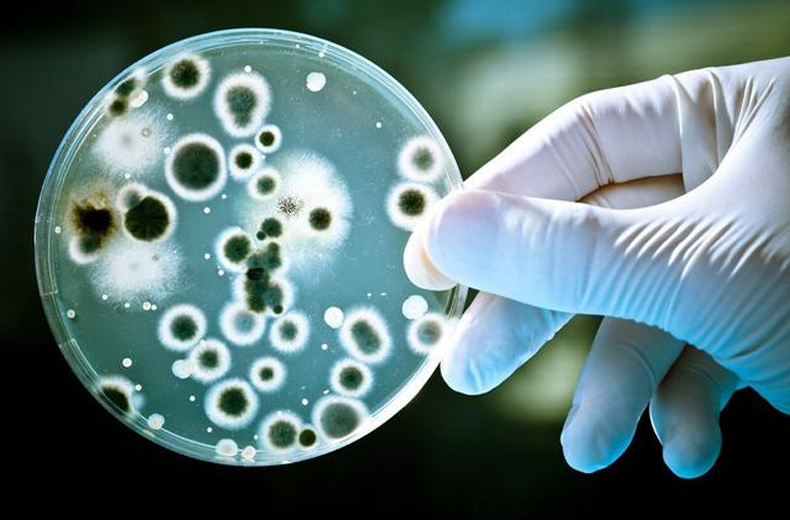
未標題-2-13.jpg

干冰清洗如何規避落菌總數超標問題?
干冰清洗如何規避落菌總數超標問題?
發布時間:2021-10-18 所屬分類:【行業動態】閱讀:2089
近年來,隨著經濟快速發展以及我國居民收入水平的穩步增長,在消費能力和消費意愿的雙重推動下,乳制品、烘焙糕點、方便食品、功能飲料、新式茶飲等食品飲料行業發展迅速,并保持兩位數的增長。與此同時,食品機械制造裝備日趨完善和技術水平的不斷提升,加快了食品飲料行業工業化進程,生產加工各環節基本實現機械化流水線作業。
食品生產流水線在食品行業加工輸送生產工藝過程中,發揮著重大作用,有著結構簡單、維修方便 、通用用性強、成本低等特點。
食品加工企業在產品生產過程中,食品生產流水線的徹底清洗非常重要。生產流水線在使用后會產生一些沉積物,如不及時徹底地清洗,將直接會影響產品的質量。導致落菌總數超標的問題。 菌落總數常常被用來判定食品被細菌污染的程度及衛生質量,對食品作出適當的衛生評價。食用菌落總數超標的食品,可能會引起急性中毒、嘔吐、腹瀉等癥狀,危害人體健康安全。產品生產線的清潔度就變得尤為重要。 目前,干冰清洗機已廣泛應用于乳品、果蔬飲料、面包烘焙、啤酒等對衛生要求非常高的加工行業。據市場反饋,干冰清洗機可實現在線快速干燥清洗,無需人工再擦洗和沖刷,并且使用靈活,不損傷設備,清洗速度快,效果好。 隨著食品質量衛生越來越受到國家和消費者關注,相關部門的監督抽查工作也日趨強化,相關食品企業也格外重視生產環節衛生問題。干冰清洗機具有無需拆卸即可在線清洗,清洗速度快、效率高,提高設備利用率,不損傷設備,清洗多變靈活、清洗污物種類多樣化。今后都是非常受歡迎的應用,而且勢必對傳統的工藝方式產生強烈沖擊。